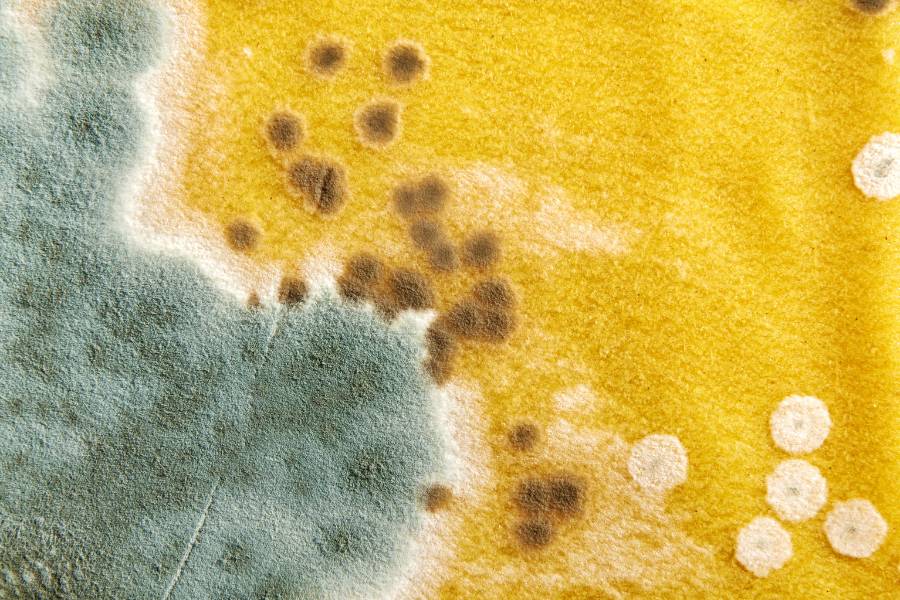

Phòng ngủ vốn là nơi để chúng ta nghỉ ngơi và tái tạo lại năng lượng đã tiêu hao trong ngày. Thế nhưng sẽ thật khó chịu nếu căn phòng của bạn có mùi hôi ẩm mốc. Dù là nguyên nhân gì đi chăng nữa thì bạn cũng hãy nên áp dụng một trong những mẹo khử mùi phòng ngủ sau đây.
Nguyên nhân khiến phòng ngủ có mùi hôi thối, ẩm mốc
Có rất nhiều nguyên nhân dẫn đến việc phòng ngủ có mùi hôi ẩm mốc, khó chịu. Thậm chí có những căn phòng trông rất sạch sẽ gọn gàng nhưng vẫn có mùi hôi. Dưới đây là một trong những nguyên nhân khiến bạn phải tiến hành khử mùi phòng ngủ:
- Mùa mưa là điều kiện thuận lợi cho các loại nấm mốc phát triển. Độ ẩm không khí cao trong không gian kín của phòng sẽ là nơi cư trú lý tưởng của các loại nấm mốc.

- Côn trùng, động vật trú trong phòng: Các loại động vật như gián, chuột,… mang trong người mùi hôi từ cơ thể và mùi hôi từ cống, rãnh, rác,… về phòng. Điều này bắt buộc bạn phải khử mùi ẩm mốc trong phòng ngủ.
- Nếu phòng ngủ của bạn có nhà vệ sinh, mùi hôi từ khu vực này cũng là một nguyên nhân có thể xảy ra. Trong quá trình phân hủy chất thải dưới hầm cầu, các khí thải không thoát được do đường thoát khí bị tắc sẽ khiến nhà vệ sinh bốc mùi khó chịu.
Mẹo khử mùi hôi, ẩm mốc trong phòng ngủ, phòng kín
Để khử mùi ẩm mốc trong phòng ngủ, bạn có thể sử dụng một trong những cách sau. Chúng chủ yếu đều là những cách làm đơn giản. Một vài nguyên liệu dùng để khử mùi phòng ngủ được đề xuất dưới đây cũng rất dễ tìm và an toàn đối với sức khỏe:
Vệ sinh thường xuyên
Trong quá trình sinh hoạt tại phòng ngủ, bụi bẩn, rác thải sẽ tồn đọng lại trong căn phòng của bạn. Lâu dần chúng sẽ gây nên mùi hôi khó chịu khi bạn bước vào.
Thế nên cách làm thơm phòng ngủ tự nhiên hiệu quả nhất là hãy vệ sinh phòng thường xuyên. Việc dọn dẹp phòng ngăn nắp, sạch sẽ cũng sẽ hạn chế được các loại nấm mốc và côn trùng đến “quấy nhiễu” sự sạch sẽ của phòng bạn.

Sử dụng quạt
Hãy nói lời “tạm biệt” mùi hôi trong phòng bằng cách sử dụng quạt hoặc máy lọc không khí. Cách khử mùi ẩm mốc trong phòng ngủ đơn giản bằng quạt. Bạn hãy đặt quạt hướng ra ở vị trí cửa sổ hoặc cửa chính của phòng.
Sau đó để cho không gian phòng thoáng và bật quạt. Không khí ám mùi hôi sẽ được quạt điều hướng thổi ra khỏi phòng.

Sử dụng máy lọc không khí
Với phương pháp dùng máy lọc không khí để làm máy khử mùi phòng ngủ. Bạn chỉ cần đóng kín phòng, sau đó khởi động máy.
Cơ chế lọc bụi, không khí của máy không chỉ mang lại cho bạn nguồn không khí trong lành mà còn trả lại cho bạn căn phòng thơm tho không một chút mùi khó chịu.
Hiện nay, giá máy lọc không khí trên thị trường dao động từ vài triệu đồng đến vài chục triệu đồng tùy vào thương hiệu và dòng máy.

Khử mùi phòng ngủ bằng trái thơm (dứa, khóm)
Sử dụng các nguyên liệu thiên nhiên để khử mùi phòng ngủ hiện nay là cách được rất nhiều người chưa chuộng. Thơm là một trong những nguyên liệu đó. Khác xa với các chất tạo mùi thơm hóa học trên thị trường: hút mùi tốt nhưng về lâu dài không tốt cho sức khỏe.
Cách khử mùi phòng ngủ bằng trái thơm: Dùng một trái thơm đã được khoét ruột bên trong. Sau đó thắp một cây nến nhỏ bỏ vào trong. Nhiệt độ cao từ nến sẽ làm nóng vỏ thơm và tạo nên mùi thơm dễ chịu. Từ đó loại bỏ các mùi hôi ám trong phòng ngủ.

Baking soda
Đây vốn là nguyên liệu được các bà nội trợ tin dùng trong việc hút ẩm, tẩy rửa, khử mùi hôi lò vi sóng,… Tính chất vật lý và hóa học tự nhiên của baking soda cũng cho phép chúng ta sử dụng chúng để khử mùi phòng ngủ.
Cách thực hiện: Đựng một lượng baking soda vào một chiếc hũ (nhựa hoặc thủy tinh đều được). Sau đó đậy chúng lại bằng nắp đậy có đục lỗ để không khí có thể lọt qua.
Nếu diện tích phòng lớn, bạn có thể đặt khoảng 2 – 3 hũ baking soda như thế. Căn phòng của bạn sẽ được khử đi những mùi hôi khó chịu. Ngoài ra, nếu muốn phòng lưu thêm mùi hương, bạn hãy cho vài giọt tinh dầu trực tiếp vào baking soda.

Khử mùi phòng ngủ bằng bã cà phê
Có thể bạn chưa biết, cà phê là nguyên liệu có tính chất bột xốp. Vì thế bã cà phê có khả năng hút ẩm và hấp thụ mùi hôi cực kỳ tốt.
Cách làm thơm phòng ngủ tự nhiên bằng bã cà phê: Cho bã cà phê đã phơi khô vào túi vải rồi cột chặt để chúng không bị rơi ra ngoài. Sau đó bạn treo túi ở khu vực thoáng đãng trong phòng ngủ. Mùi thơm của cà phê sẽ đánh bay những mùi khó chịu trong phòng ngủ. Ngoài ra, khả năng hút ẩm cao của cà phê cũng sẽ góp phần ngăn chặn sự phát triển của nấm mốc gây hôi phòng.

Tham khảo thêm: Những Cách Khử Mùi Bằng Bã Cà Phê Không Phải Ai Cũng Biết
Long não
Long não (băng phiến) là nguyên liệu quen thuộc của rất nhiều bà nội trợ. Bạn có thể dễ dàng bắt gặp chúng ở các cửa hàng. Chúng được biết đến với công dụng là chất tạo mùi thơm, hút ẩm và xua đuổi côn trùng cực hiệu quả trong gia đình. Nếu muốn tìm kiếm một giải pháp khử mùi phòng ngủ nhanh chóng nhất. Bạn chỉ cần “trang bị” một túi long não rồi treo ở nơi góc phòng là được.

Hoa tươi
Nếu bạn là người yêu vẻ đẹp của hoa thì đây cũng chính là giải pháp cho bạn khử mùi phòng ngủ tự nhiên. Hoa không chỉ mang vẻ đẹp về hình thức, nhiều loại hoa với mùi hương tinh tế dễ chịu còn có thể loại bỏ được mùi hôi khó chịu trong không gian kín.
Từ đó giúp tinh thần của con người trở nên thư giãn, thoải mái hơn. Một vài loại hoa có mùi dễ chịu mà chúng ta có thể đặt trong phòng là hoa oải hương (lavender), hoa hồng, hoa hương thảo,…

Cây xanh
Một nghiên cứu của NASA đã chỉ ra, các loài cây cảnh trồng trong nhà có khả năng loại bỏ đến 87% không khí bị ô nhiễm chỉ trong 24 tiếng đồng hồ. Vì thế, trồng cây xanh trong phòng ngủ chính là bạn đang có một cỗ máy khử mùi phòng ngủ thành công, tận hưởng nguồn không khí trong lành.
Và lại còn có thêm vật trang trí cho căn phòng thêm đẹp. Một số loại cây đặt trong phòng ngủ có thể kể đến như: dương xỉ, thường xuân, thiết mộc lan, vạn niên thanh,…

Thảo mộc khô
Thảo mộc khô là loại nguyên liệu lành tính với người sử dụng. Bạn có thể dùng một số loại thảo mộc như: sả, quế, cỏ xạ hương, hương thảo, bạc hà,…
Cách sử dụng: Bạn chỉ cần cho các loại thảo mộc mà mình đã chọn vào túi vải hoặc một chiếc hũ không đậy nắp. Sau đó treo ở nơi thích hợp hoặc đặt ở một vị trí dễ thấy trong căn phòng.

Lá dứa khử mùi phòng ngủ
Đặc trưng của lá dứa là mùi hương dịu nhẹ dễ chịu khó có thể lẫn với bất kỳ loài thực vật nào khác. Lá dứa từ lâu được xem là nguyên liệu khử mùi phòng ngủ tự nhiên hiệu quả. Không những thế, chúng còn được tin là có khả năng xua đi những nguồn năng lượng xấu, thanh lọc không khí cho căn phòng.
Cách khử mùi ẩm mốc trong phòng ngủ với lá dứa: Mua một bó lá dứa tươi. Số lượng lá dứa nhiều hay ít, to hay nhỏ là tùy thuộc vào diện tích căn phòng. Rửa sạch lá, sau đó cắt ra thành từng đoạn dài tầm 10cm rồi cho vào túi lưới treo trong phòng ngủ.

Dùng sả
Đây là nguyên liệu không còn xa lạ với những ai muốn khử mùi các không gian trong nhà. Không chỉ khử mùi hiệu quả, sả còn có tác dụng xua đuổi côn trùng, sát khuẩn hiệu quả. Để khử mùi phòng ngủ tự nhiên bằng sả, bạn có thể sử dụng một trong hai cách sau:
- Dùng củ sả nguyên chất: Chuẩn bị một bó sả từ 5 – 8 cây nhỏ. Bỏ phần lá, giữ phần thân, rửa sạch rồi treo bó sả trên cao trong phòng. Đập dập củ sả nếu muốn hương thơm từ sả lan tỏa nhiều hơn.
- Dùng tinh dầu sả: Cho một lượng tinh dầu sả vào hòa cùng nước lạnh. Sau đó cho vào bình xịt và lắc đều để dung dịch hòa lẫn vào nhau. Sau đó xịt lên không khí trong phòng. Xịt vào buổi sáng và buổi tối để căn phòng được khử mùi hoàn toàn và giúp bạn có được giấc ngủ ngon.

Nếu bạn quá bận rộn để dành thời gian dọn dẹp nhà cửa, hãy đặt ngay dịch vụ giúp việc nhà theo giờ của bTaskee. Các chị CTV sẽ mang lại cho bạn không gian nhà cửa sạch bong chỉ với một nốt nhạc.
Tải app bTaskee tại đây
Báo cũ
Dù không mang lại mùi thơm như các nguyên liệu khác nhưng báo cũ lại có tác dụng hút ẩm và hút mùi hôi rất tốt. Đó chính là lý do vì sao người ta thường nhét những tờ báo cũ vào thân giày để chống ẩm mốc và mùi hôi.
Cách làm thơm phòng ngủ tự nhiên bằng báo cũ rất đơn giản. Bạn chỉ cần phủ giấy báo lên những nơi bị ẩm mốc trong nhà: tủ quần áo, tủ giày, góc phòng, gầm bàn,… Tuy nhiên, bạn cần lót khăn giấy hoặc vải ở những nơi đặt giấy báo. Vì mực báo có thể lem và làm bẩn các vật dụng khác trong căn phòng.

Than củi
Than củi được cấu tạo từ cacbon. Chúng có khả năng hấp thụ tất cả các phân tử hữu cơ. Do đó, than củi có thể loại bỏ bất kỳ hạt hữu cơ có mùi nào mà nó gặp trong không khí. Vì thế, than củi được xem là một chất khử mùi cực kỳ hiệu quả.
Than củi vốn được nhiều bà nội trợ tin dùng trong việc khử mùi tủ lạnh, nhà vệ sinh. Thế nên chẳng có vấn đề gì nếu chúng ta tận dụng nguyên liệu này vào việc khử mùi ẩm mốc phòng máy lạnh. Hãy đặt một vài hòn than củi lên chiếc đĩa. Đặt chúng ở nơi cao ráo trong phòng và chờ mùi hôi dần được loại bỏ.

Rượu Vodka
Rượu Vodka có khả năng khử mùi rất tốt và đặc biệt không lưu lại mùi rượu trên các bề mặt đã tiếp xúc. Vì thế bạn có thể khử mùi phòng ngủ với rượu Vodka bằng cách sau:
- Hòa tan dung dịch rượu Vodka và nước sạch với tỷ lệ 1:1
- Cho dung dịch vào bình xịt và xịt trong không gian phòng 2 lần/ngày.

Giấm trắng
Nhiều nghiên cứu về giấm đã chứng minh giấm có khả năng khử mùi hiệu quả. Mùi hôi trong căn phòng của bạn sẽ được loại bỏ bởi thành phần axit axetic có trong giấm. Công thức như sau:
- Pha nước với giấm theo tỷ lệ 1:1, sau đó cho hợp chất vào bình xịt.
- Xịt dung dịch đã pha lên mọi ngóc ngách của phòng ngủ.
Lưu ý: Vì tính axit của giấm nên khi sử dụng giấm, bạn cần tránh xịt chúng lên những nơi có kim loại. Tránh cho các vật dụng này bị hao mòn, xỉn màu bởi giấm.

Tinh dầu
Tinh dầu hiện nay là một phương pháp khử mùi phòng ngủ được nhiều gia đình lựa chọn. Không khó để bắt gặp các sản phẩm tinh dầu, máy khuếch tán, máy xông ở khắp các cửa hàng, siêu thị hay các trang bán hàng trực tuyến.
Sử dụng tinh dầu là một cách hiệu quả bởi chúng chiết xuất từ các loại cây cỏ thiên nhiên. Bên cạnh tác dụng loại bỏ mùi hiệu quả, tinh dầu còn có thể diệt khuẩn và giúp chất lượng không khí trong phòng tốt hơn, mang đến cảm giác thư thái, dễ chịu cho mọi người.

Vỏ cam, vỏ quýt
Nhiều nghiên cứu khoa học đã cho thấy, vỏ cam có nhiều tinh dầu. Trong vỏ quả cam chứa hơn 60 loại flavonoid và 170 loại phytonutrients (hóa chất thực vật) khác nhau. Ngoài ra, vỏ cam cũng có một lượng lớn pectin, vitamin. Tất cả những thành phần trên giúp vỏ cam có khả năng khử mùi hôi hiệu quả.
Chẳng cần thiết bị hay máy khử mùi phòng ngủ, bạn chỉ cần sử dụng vỏ cam, vỏ quýt. Đầu tiên là chuẩn bị vỏ cam/quýt. Sau đó đặt một ít muối vào vỏ cam. Nếu vỏ bị vụn, bạn có thể trộn lẫn muối và vỏ với nhau. Cho chúng vào một chiếc dĩa và đặt lên bàn hoặc nơi cao trong phòng ngủ.

Nến thơm
Không chỉ giúp bạn thư giãn, nến thơm còn có khả năng khử mùi phòng ngủ và loại bỏ ẩm mốc. Những loại mùi đáng ghét như mùi thuốc lá, mùi thức ăn còn vương lại trong phòng sẽ biến mất nhờ tác dụng khử mùi của nến thơm.
Tuy nhiên, cách làm này yêu cầu sự cẩn thận của bạn. Hãy đốt nến và đặt ở nơi an toàn, tránh xa tầm tay trẻ nhỏ và các vật dụng dễ gây cháy nhé.

Tham khảo thêm: Cách Làm Sáp Thơm Để Phòng Đơn Giản
Nước hoa xịt phòng ngủ
Nếu bạn là người ưa thích mùi nước hoa. Khử mùi phòng ngủ sẽ là công việc cực kỳ đơn giản bởi hiệu quả tức thời mà nó mang lại.
Bạn có thể mua các sản phẩm nước hoa xịt phòng ngủ ở các cửa hàng, siêu thị và làm theo hướng dẫn sử dụng của từng sản phẩm.

Nước cốt chanh
Chanh là loại quả chứa acid citric dồi dào. Lượng axit này có thể lên đến 8%. Chất này có thể tẩy tế bào chết và loại bỏ mùi hôi khó chịu. Không những thế, quả chanh còn có tính sát trùng nhẹ. Từ đó kìm hãm và ức chế sự hoạt động của vi khuẩn. Thế nên quả chanh được nhiều bà nội trợ tin dùng để khử mùi máy lạnh, khử mùi lò vi sóng và khử mùi phòng ngủ tự nhiên.

Cách làm thơm phòng ngủ tự nhiên: Dùng 2 – 3 quả chanh vắt lấy nước rồi cho vào bình xịt. Tiến hành xịt xung quanh không gian phòng. Muốn phát huy hiệu quả khử mùi tốt hơn, bạn có thể cho thêm một ít muối nở rồi hòa tan dung dịch với nhau và thực hiện xịt phòng.
Khử mùi mốc trong quần áo
Rất có thể mùi hôi trong căn phòng bạn bắt nguồn từ những lớp áo bị ẩm mốc. Để loại bỏ mùi hôi này, cách tốt nhất là bạn hãy chăm sóc áo quần thật kỹ.
Hãy giặt giũ trang phục kỹ càng, loại bỏ hoàn toàn mùi hôi và vết bẩn. Tránh đem áo quần vào phòng khi chưa khô hẳn.
Giấy thơm
Giấy thơm là vật dụng tạo hương ưa chuộng mà nhiều người lựa chọn đặt trong phòng ngủ. Với giá thành rẻ, chỉ từ 50 đến 100 ngàn đồng, bạn có thể sở hữu nhiều loại giấy với mùi hương khác nhau.

Các loại giấy thơm thường được làm từ những tinh dầu thiên nhiên như tinh dầu hoa hồng, tinh dầu chanh, tinh dầu bạc hà… Bạn có thể đặt chúng trong tủ quần áo, trong hộp đựng giày dép, trên bàn làm việc hoặc bất cứ đâu.
Phòng tránh mùi hôi quay lại trong phòng ngủ
Mùi hôi trong phòng ngủ không chỉ khiến chúng ta thấy khó chịu mà còn ảnh hưởng không ít đến hô hấp và sức khỏe. Từ những nguyên nhân gây nên mùi hôi, bạn hãy thực hiện những cách phòng ngừa mùi hôi quay lại phòng ngủ như sau:
- Thường xuyên dọn dẹp phòng, sắp xếp tủ quần áo ngăn nắp
- Không đem các vật ẩm ướt vào phòng
- Hình thành lối sống ngăn nắp, hạn chế để rơi thức ăn, rác trong phòng
- Vệ sinh máy lạnh (nếu có) định kỳ, tránh mùi hôi phát ra từ máy lạnh

Phòng ngủ là nơi chúng ta nghỉ ngơi sau một ngày học tập và làm việc căng thẳng. Thế nên đừng tự “phá hủy” đi không gian thư giãn của mình chỉ vì những mùi hôi khó chịu.
Câu hỏi thường gặp
- Làm thế nào ngăn chặn mùi hôi trong phòng ngủ?
Một số chất khử mùi hôi tốt như cà phê, trà, baking soda, thảo mộc khô, hoa tươi,… Để một bát đựng bất kỳ chất hút mùi nào trong số này trong phòng để làm sạch một chút sẽ giúp loại bỏ những mùi khó chịu trong không khí.
- Cái gì giúp hấp thụ mùi trong phòng ngủ tốt nhất?
Baking soda rất hiệu quả trong việc hút mùi từ không khí cũng như từ các bề mặt. Ngoài ra, nếu muốn phòng lưu thêm mùi hương, bạn hãy cho vài giọt tinh dầu trực tiếp vào baking soda.
- Làm thế nào để phòng ngủ có hương thơm tự nhiên?
Cách hiệu quả nhất đó là bạn hãy vệ sinh phòng ngủ của mình hằng ngày. Ngoài ra bạn có thể sử dụng một số công cụ, nguyên liệu hỗ trợ như máy lọc không khí, túi cà phê, tinh dầu sả, nến thơm,…
Khử mùi phòng ngủ, dọn dẹp nhà cửa thường xuyên không chỉ giúp không gian sống của bạn sạch sẽ mà còn góp phần bảo vệ sức khỏe. Cùng bắt tay vào thực hiện những cách khử mùi ẩm mốc trong phòng ngủ trên nhé. Chúc bạn thành công!
Xem thêm bài viết:
- 13 Cách Làm Thơm Phòng Tự Nhiên, Lưu Hương Dài Lâu
- 12 Cách Khử Mùi Ẩm Mốc Trong Phòng Kín Đơn Giản Mà Hiệu Quả
- 5 Mẹo Dọn Dẹp Nhà Cửa Sạch Bong Thần Tốc








